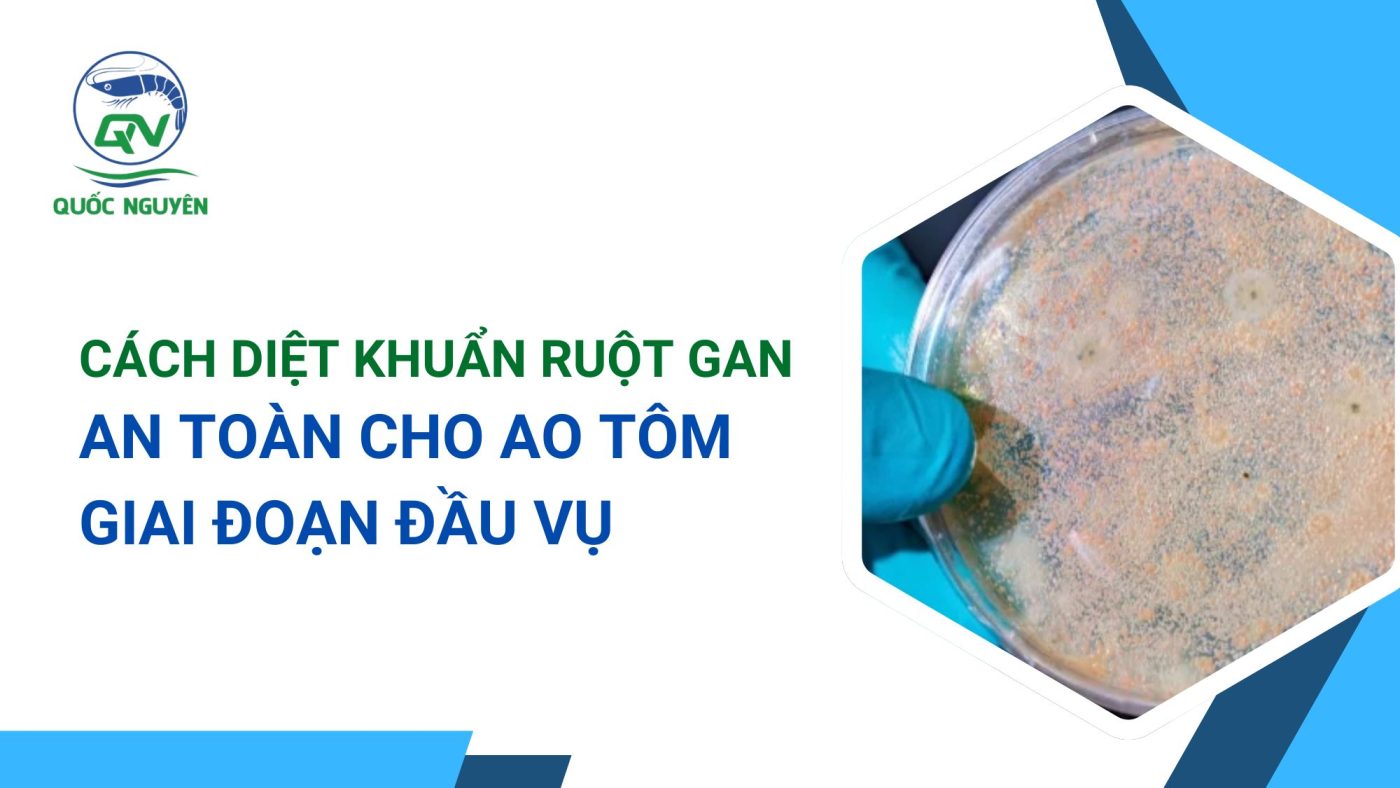

Tôm mới thả được vài ngày nhưng anh chị đi kiểm tra mẫu nước thấy khuẩn lên đặc đĩa thạch. Đứng trước cái khó là tạt thuốc diệt khuẩn thì sợ tôm còn nhỏ quá sẽ bị sốc. Nhưng nếu không tạt, khuẩn tấn công làm hư hại gan ruột thì coi như mất trắng cả vụ nuôi. Nỗi lo này không của riêng ai, đặc biệt là khi áp lực môi trường trong nuôi tôm ngày càng khắc nghiệt, chi phí đầu tư thì ngày một tăng cao.
Việc xác định đúng thời điểm và cách thức tác động vào môi trường nước là yếu tố sống còn để bảo vệ đàn tôm khỏi những tác nhân gây hại ngay từ giai đoạn đầu. Hiểu được sự lo lắng của anh chị về độ an toàn của đàn tôm nhỏ, bài viết dưới đây sẽ chia sẻ chi tiết về kinh nghiệm diệt khuẩn ruột và diệt khuẩn gan sao cho đạt hiệu quả mà vẫn giữ cho ao tôm khỏe, tôm ăn mạnh.
1. Dấu hiệu nhận biết thực tế cần diệt khuẩn tại ao
Khi nào chúng ta cần bắt tay vào việc xử lý khuẩn? Thay vì đoán mò, anh chị nên quan sát những biểu hiện trực quan ngay tại ao nuôi, đem nước đi kiểm tra để có quyết định chính xác nhất.
- Quan sát trạng thái tôm: Khi kiểm tra thân tôm, anh chị thấy gan nhợt nhạt, ruột đứt khúc hoặc trống thức ăn. Đây là những tín hiệu cho thấy khuẩn hại đang tấn công trực tiếp vào hệ tiêu hóa của tôm.
- Quan sát màu nước và bọt ao: Trong mùa nắng nóng, nếu nước ao chuyển sang màu xanh đậm quá nhanh, xuất hiện nhiều bọt nhớt lâu tan ở cuối góc ao, hoặc nước có mùi tanh nồng. Đây thường là dấu hiệu của sự dư thừa hữu cơ và khuẩn Vibrio đang bùng phát mật số rất cao.
- Kiểm tra định kỳ bằng đĩa thạch: Nếu anh chị mang mẫu nước đi kiểm tra mà khuẩn xanh, khuẩn vàng xuất hiện dày đặc, vượt ngưỡng an toàn (thường trên 1000 CFU/ml đối với tôm nhỏ). Lúc này, việc diệt khuẩn ruột và diệt khuẩn gan là yêu cầu bắt buộc để góp phần kiểm soát dịch bệnh trong ao tôm.

2. Nguyên nhân cốt lõi khiến khuẩn bùng phát mạnh
Việc thấu hiểu nguyên nhân sẽ giúp anh chị không chỉ biết cách xử lý mà còn biết cách phòng ngừa chủ động hơn.
- Áp lực từ mùa nắng nóng: Nhiệt độ nước tăng cao trên 30 độ C là môi trường lý tưởng để vi khuẩn hại nhân mật số theo cấp số nhân. Nắng gắt làm tảo phát triển mạnh, khi tảo tàn đột ngột sẽ tạo ra lượng hữu cơ khổng lồ, làm thức ăn cho khuẩn hại bùng nổ.
- Giai đoạn giao mùa và mưa dầm: Những cơn mưa bất chợt làm pH và độ mặn thay đổi đột ngột. Sự biến động môi trường làm tôm bị stress, giảm sức đề kháng, tạo cơ hội cho khuẩn cơ hội xâm nhập và gây tổn thương hệ thống gan ruột.
- Quản lý thức ăn và đáy ao: Thức ăn dư thừa tích tụ lâu ngày dưới đáy ao mà không được xử lý vi sinh định kỳ sẽ trở thành “ổ bệnh”. Khuẩn hại từ đáy ao sẽ lơ lửng trong nước và xâm nhập vào cơ thể tôm thông qua việc tôm ăn xác hữu cơ hoặc hấp thụ qua mang.
3. Cách xử lý thực tế giúp diệt khuẩn an toàn
Nhiều anh chị thắc mắc tôm bao nhiêu ngày mới diệt khuẩn được?
Câu trả lời là: Hạn chế diệt khuẩn trước 7 ngày tuổi. Tuy nhiên, từ ngày thứ 10 trở đi, nếu khuẩn cao, anh chị cần thực hiện quy trình sau để đảm bảo an toàn.
Bước 1 – Đo đạc và đánh giá: Trước khi tạt bất kỳ loại thuốc nào, anh chị cần kiểm tra các chỉ số môi trường như pH, kiềm và mật độ khuẩn. Tuyệt đối không diệt khuẩn khi tôm còn nhỏ, bước vào chu kỳ lột xác rộ vì lúc này vỏ tôm còn mềm, tôm rất dễ bị sốc và rớt.
Bước 2 – Chọn thời điểm và liều lượng: Nên chọn thời điểm trời mát, thường là vào lúc 8-9 giờ sáng hoặc sau 5 giờ chiều, tuỳ dòng diệt khuẩn.
Bước 3 – Hỗ trợ hồi phục hệ vi sinh: Sau khi diệt khuẩn ruột và diệt khuẩn gan khoảng 24 đến 48 giờ, anh chị bắt buộc phải cấy lại vi sinh liều cao. Việc này giúp ổn định lại hệ đệm sinh học, không cho khuẩn hại có cơ hội bùng phát trở lại từ những xác hữu cơ trong ao.
4. Những sai lầm phổ biến khiến tôm bị sốc khi diệt khuẩn
Trong quá trình đồng hành cùng anh chị, chúng tôi nhận thấy có những thói quen diệt khuẩn tưởng chừng như đúng nhưng lại gây hại rất lớn cho đàn tôm nhỏ.
- Diệt khuẩn liều cao khi tôm mới thả: Một số anh chị quá lo lắng nên tạt thuốc sát trùng liều nặng khi tôm chưa đầy 10 ngày tuổi. Điều này làm tôm bị sốc, sức đề kháng suy giảm và dẫn đến tôm rớt lai rai.
- Không cấy lại vi sinh sau khi diệt: Sau khi diệt khuẩn ao tôm, môi trường nước gần như trở thành “vùng trống”. Nếu anh chị không đưa vi sinh có lợi vào ngay, khuẩn hại (vốn có tốc độ sinh sản nhanh hơn) sẽ chiếm lấy môi trường và tấn công tôm mạnh hơn gấp nhiều lần.

5. Giải pháp từ Thủy Sản Quốc Nguyên
Để hỗ trợ anh chị nuôi tôm an toàn, hiệu quả, Thủy sản Quốc Nguyên xin giới thiệu những dòng sản phẩm chuyên biệt, được thiết kế để bảo vệ gan và ruột tôm một cách êm dịu nhất.
- Sử dụng Vimekon cho tôm nhỏ: Đây là dòng sát trùng phổ rộng nhưng cực kỳ an toàn. Vimekon giúp kiểm soát mật độ khuẩn hại trong nước mà không làm sốc tôm, ngay cả đối với tôm nhỏ. Sản phẩm góp phần diệt vi khuẩn gây bệnh gan, gây ra hiện tượng gan nhợt nhạt và ruột đứt khúc.
- Dine Clear – Giải pháp diệt khuẩn mạnh và ký sinh trùng: Khi tôm lớn hơn và áp lực khuẩn quá cao, Dine Clear là lựa chọn tối ưu. Với công thức Iodine nồng độ chuẩn, sản phẩm giúp diệt khuẩn gan và diệt khuẩn ruột hiệu quả, đồng thời hỗ trợ xử lý các loại ký sinh trùng lơ lửng trong nước, giúp môi trường ao nuôi thông thoáng.
- Quy trình kết hợp thông minh: anh chị nên luân phiên sử dụng các dòng diệt khuẩn để tránh tình trạng lờn thuốc. Việc kết hợp đúng liều lượng Vimekon hoặc Dine Clear theo hướng dẫn của kỹ thuật viên sẽ giúp ổn định sức khỏe đàn tôm suốt mùa nắng nóng và mùa mưa dầm.
Kết luận
Nuôi tôm là một nghề đòi hỏi sự tỉ mỉ và thấu hiểu. Diệt khuẩn ruột và diệt khuẩn gan không đơn thuần là tạt thuốc xuống ao, mà là quản lý môi trường sao cho tôm luôn trong môi trường tốt nhất để phát triển.
Nếu có bất kỳ thắc mắc nào về kỹ thuật xử lý ao, vui lòng liên hệ SĐT/Zalo: 096.886.7577 – Thủy Sản Quốc Nguyên sẵn sàng hỗ trợ anh chị tận tình, nhanh chóng nhất có thể!